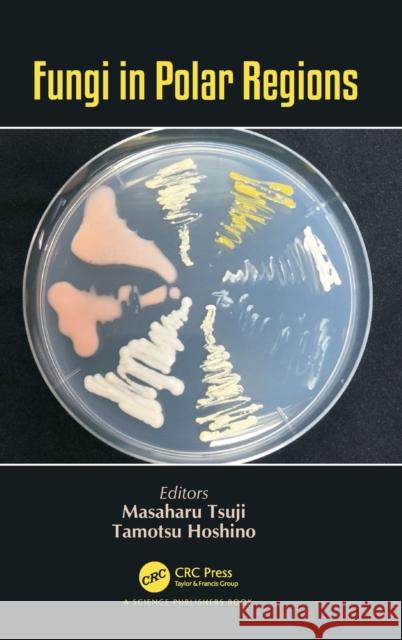
Fungi in Polar Regions Masaharu Tsuji Tamotsu Hoshino 9781138089709 CRC Press

» książki » Science - Life Sciences - Biology
 |
Genetics and biogenesis of mitochondria. Proceedings of a colloquium held at Schliersee, Germany, August 1977
ISBN: 9783110073218 / Angielski / Twarda / 689 str. Termin realizacji zamówienia: ok. 5-8 dni roboczych. |
cena:
888,11 |
 |
Handbook of Zoology/ Handbuch der Zoologie, Tlbd/Part 31, Hymenoptera, Unterordnung Symphyta
ISBN: 9783110127393 / Niemiecki / Twarda / 136 str. Termin realizacji zamówienia: ok. 5-8 dni roboczych. The renowned German reference work The Handbuch der Zoologie/Handbook of Zoology was founded in the 1920's by Professor Willi Kukenthal in Berlin and treated the complete animal kingdom from single cell organisms to mammals in eight thematic volumes: Volume I Protozoa, Porifera, Colenteratea, Mesozoa (1925); Volume II Worms (1933/34); Volume III Arthropoda ex. Insecta (1927/1932); Volume IV Arthopoda: Insecta; Volume V Solenogastres, Mollusca, Echinoderma (1925); Volume VI Pisces / Amphibia (1930); Volume VII Reptilia / Aves (1931); Volume VIII Mammalia. The Volumes Insecta (Eds. N.P.... The renowned German reference work The Handbuch der Zoologie/Handbook of Zoology was founded in the 1920's by Professor Willi Kukenthal in Berlin a... |
cena:
888,11 |
 |
Lähme Der Füllen - Luscitas
ISBN: 9783111039213 / Niemiecki / Twarda / 686 str. Termin realizacji zamówienia: ok. 5-8 dni roboczych. |
cena:
888,11 |
 |
Butterfly Biology Systems: Connections and Interactions in Life History and Behaviour
ISBN: 9781789243574 / Angielski / Twarda / 472 str. Termin realizacji zamówienia: ok. 5-8 dni roboczych. |
cena:
891,85 |
 |
The Biology of Apples and Pears
ISBN: 9780521380188 / Angielski / Twarda / 502 str. Termin realizacji zamówienia: ok. 5-8 dni roboczych. This comprehensive reference on all aspects of pomology at the organ, tree and orchard level describes the main varieties and rootstocks, and the factors controlling their growth, cropping, fruit quality, storage life, fertilizer and irrigation needs. It emphasizes the principles underlying modern high-density planting and the production of fruits in environments ranging from temperate to tropical. The book will be suitable for fruit farmers and technical advisors as well as scientific researchers and students of pomology and horticulture.
This comprehensive reference on all aspects of pomology at the organ, tree and orchard level describes the main varieties and rootstocks, and the fact...
|
cena:
892,53 |
 |
Fungal Families of the World
ISBN: 9780851998275 / Angielski / Twarda / 456 str. Termin realizacji zamówienia: ok. 5-8 dni roboczych. Fungal Families of the World portrays the immense diversity of the Kingdom Fungi. As well as basic information on all currently recognized families, detailed entries are provided on over 250 key families, describing their morphology, ecology, phylogeny, distribution and economic significance.
Key Features: 536 fungal families included, some published in 2007 New A4 format' Nearly 900 full color illustrations Carefully selected references to aid further reading Fungal Families of the World portrays the immense diversity of the Kingdom Fungi. As well as basic information on all currently recognized famil...
|
cena:
893,19 |
 |
Introduction to Wildlife and Fisheries (Paperback)
ISBN: 9781464109133 / Angielski / Miękka / 512 str. Termin realizacji zamówienia: ok. 5-8 dni roboczych. |
cena:
893,97 |
 |
Compact Stars: The Quest for New States of Dense Matter - Proceedings of the Kias-Apctp International Symposium on Astro-Hadron Physics
ISBN: 9789812389541 / Angielski / Twarda / 544 str. Termin realizacji zamówienia: ok. 5-8 dni roboczych. Space observations are currently providing a glimpse of various new states of matter possibly present in compact stars, with terrestrial laboratories producing compelling evidence in support. The aim of this book is to facilitate the exchange of ideas -- both established and emergent, both theoretical and experimental -- in the areas of the physics of neutrinos, dense hadronic matter and compact stars.
Space observations are currently providing a glimpse of various new states of matter possibly present in compact stars, with terrestrial laboratories ...
|
cena:
896,28 |
 |
Developmental Biology: Volume 7
ISBN: 9781559383127 / Angielski / Twarda / 248 str. Termin realizacji zamówienia: ok. 5-8 dni roboczych. The seventh volume of a multi-volume work designed for medical students with rudimentary knowledge of cellular biology. It is the key discipline for the basic medical sciences and clinical medicine to be taught in an integrated curriculum. This text features developmental biology. The seventh volume of a multi-volume work designed for medical students with rudimentary knowledge of cellular biology. It is the key discipline fo... |
cena:
896,46 |
 |
Reproduction, Larval Biology, and Recruitment of the Deep-Sea Benthos
ISBN: 9780231080040 / Angielski / Twarda / 336 str. Termin realizacji zamówienia: ok. 5-8 dni roboczych. This study explores the most fundamental biological processes in the largest and least understood habitat on earth- the deep sea. The fifteen chapters assemble an impressive list of contributers, including prominent reproductive biologists, oceanographers, and larval ecologists, to illuminate the many levels of biological integration from the cell to the community, and covering most major phyla of marine invertebrates.
This study explores the most fundamental biological processes in the largest and least understood habitat on earth- the deep sea. The fifteen chapters...
|
cena:
896,46 |
 |
Molecular Mechanisms in Plant Adaptation
ISBN: 9781118860175 / Angielski / Twarda / 256 str. Termin realizacji zamówienia: ok. 5-8 dni roboczych. Plants are forced to adapt for a variety of reasons-- protection, reproductive viability, and environmental and climatic changes. Computational tools and molecular advances have provided researchers with significant new insights into the molecular basis of plant adaptation. Molecular Mechanisms in Plant Adaptation provides a comprehensive overview of a wide variety of these different mechanisms underlying adaptation to these challenges to plant survival. Molecular Mechanisms in Plant Adaptation opens with a chapter that explores the latest technological advances used... Plants are forced to adapt for a variety of reasons-- protection, reproductive viability, and environmental and climatic changes. Computational too... |
cena:
896,79 |
 |
Human Reproduction: Updates and New Horizons
ISBN: 9781118849583 / Angielski / Twarda / 432 str. Termin realizacji zamówienia: ok. 5-8 dni roboczych. In vitro fertilization (IVF) and other assisted reproductive technologies (ART) have become a significant part of human reproduction, with already one in 50 children worldwide being born through ART and the demand steadily increasing. To accommodate the various kinds of infertility problems, new methods have been developed to increase IVF and ART success rates and it has also become possible to treat sperm, eggs, and embryos in culture to improve reproductive success, to increase the health state of an embryo, and to prevent disease in the developing child. Human Reproduction:... In vitro fertilization (IVF) and other assisted reproductive technologies (ART) have become a significant part of human reproduction, with already ... |
cena:
896,79 |
 |
Recent Advances in Polyphenol Research, Volume 6
ISBN: 9781119427933 / Angielski / Twarda / 432 str. Termin realizacji zamówienia: ok. 5-8 dni roboczych. |
cena:
900,93 |
 |
The Common Marmoset in Captivity and Biomedical Research
ISBN: 9780128118290 / Angielski / Twarda / 570 str. Termin realizacji zamówienia: ok. 5-8 dni roboczych. |
cena:
901,18 |
 |
Primary Succession and Ecosystem Rehabilitation
ISBN: 9780521800761 / Angielski / Twarda / 458 str. Termin realizacji zamówienia: ok. 5-8 dni roboczych. This volume provides the first comprehensive summary of how plant, animal, and microbial communities develop under the harsh conditions following dramatic natural disturbances. The authors examine the basic principles that determine ecosystem development and apply the general rules to the urgent practical need for promoting the reclamation of damaged lands. Written for ecologists concerned with disturbance, landscape dynamics, restoration, life histories, invasions, modeling, soil formation and community or population dynamics, this book also serves as an authoritative text for graduate...
This volume provides the first comprehensive summary of how plant, animal, and microbial communities develop under the harsh conditions following dram...
|
cena:
901,81 |
 |
Practical HPLC Method Development
ISBN: 9780471007036 / Angielski / Twarda / 800 str. Termin realizacji zamówienia: ok. 5-8 dni roboczych. High Performance Liquid Chromatography (HPLC) is a common method for analyzing substances and is used by researchers to measure the amount of caffeine in coffee, for example, or the level of penicillin in a blood sample. The process involves separating a substance into its individual components and then examining the result.
High Performance Liquid Chromatography (HPLC) is a common method for analyzing substances and is used by researchers to measure the amount of caffeine...
|
cena:
901,95 |
|
Fungi in Polar Regions
ISBN: 9781138089709 / Angielski / Twarda / 146 str. Termin realizacji zamówienia: ok. 5-8 dni roboczych. |
cena:
902,21 |
 |
Good Microbes in Medicine, Food Production, Biotechnology, Bioremediation, and Agriculture
ISBN: 9781119762546 / Angielski / Twarda / 656 str. Termin realizacji zamówienia: ok. 5-8 dni roboczych. |
cena:
902,21 |
 |
Heavy Metals in Water: Presence, Removal and Safety
ISBN: 9781849738859 / Angielski / Twarda / 366 str. Termin realizacji zamówienia: ok. 5-8 dni roboczych. Contamination of drinking water is a worldwide problem, and ongoing work is taking place across the globe to address the issues affecting this precious commodity. Focussing on the presence of heavy metals in water, this book addresses the opportunities and challenges of this important area of research. Written and edited by experts working within the area the book highlights new techniques and research methodologies used to treat the widespread issue of dissolved heavy metals in drinking water supplies. The text covers a wide range of topics, including biofilterations, use of... Contamination of drinking water is a worldwide problem, and ongoing work is taking place across the globe to address the issues affecting this prec... |
cena:
902,21 |
 |
Microbial Systematics: Taxonomy, Microbial Ecology, Diversity
ISBN: 9780367148010 / Angielski / Twarda / 212 str. Termin realizacji zamówienia: ok. 5-8 dni roboczych. |
cena:
906,08 |













